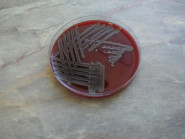
IMUNOBACT s.r.o.

IMUNOBACT s.r.o.
Mikrobiologická laboratoř.
- IČ: 64052435
|
Adresa provozovny
Sídlo společnosti |
Kamenická 566/42, 40502 Děčín
Evropská 2589/33b, 16000 Praha |
|
Telefon
|
+420 412 514 457 |
|
Telefon
|
+420 412 514 457 |
|
E-mail
|
[email protected] |
|
Web
|
www.imunobact.unas.cz |
Fotografie této firmy
* Informace o této společnosti pochází z veřejně dostupných zdrojů a rejstříků a nemusí být zcela přesné.




